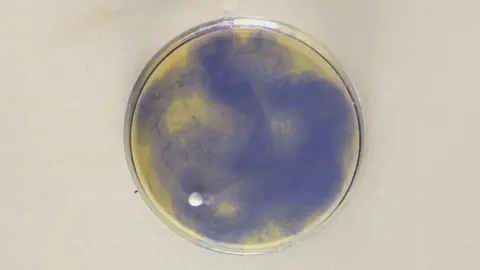

🩻🪼DAISY🪼🩻
Region: US
Wednesday 27 August 2025 15:48:00 GMT
193
8
6
0
Music
Download
Comments
kiera🪼 :
omg i didn’t even recognise you , OKAY MRS BADDIEEEEE
2025-08-27 17:09:17
1
:
2025-08-27 16:10:07
1
To see more videos from user @hellot_itties, please go to the Tikwm
homepage.